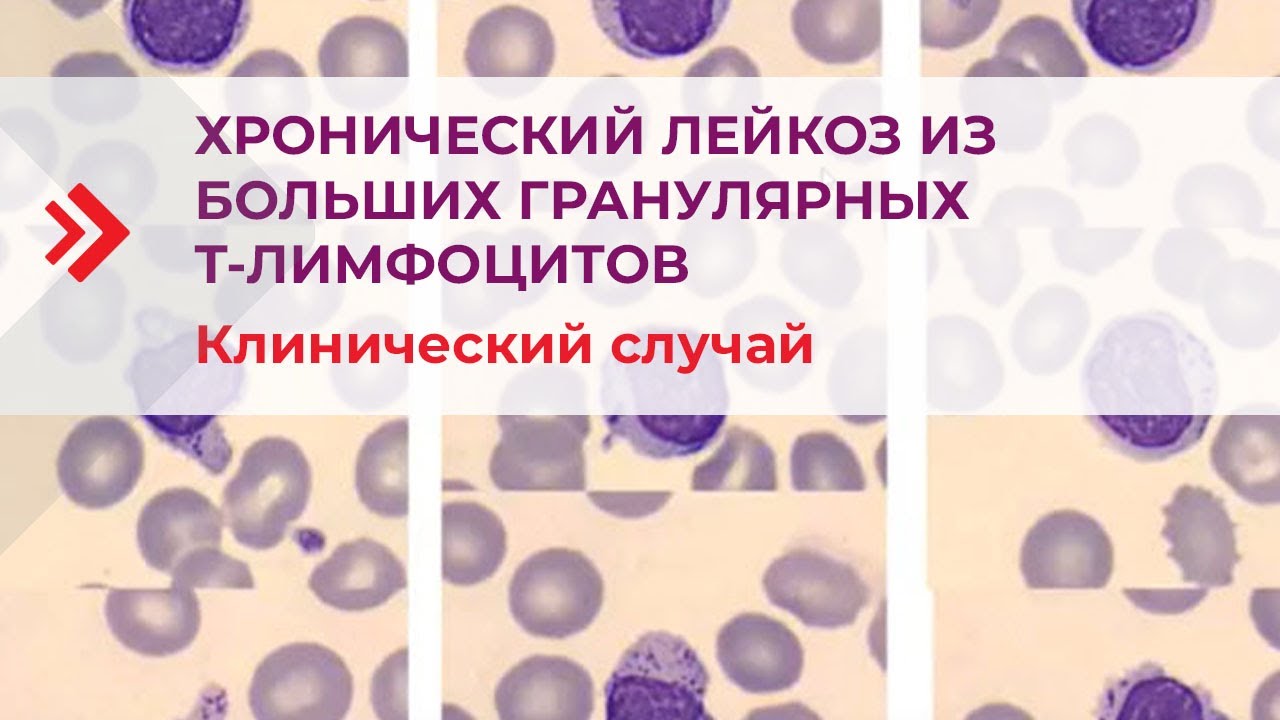

Большие гранулярные лимфоциты
Выравнивание тела это
Язык в игре найди слова
Составление и оформление приказов по личному составу
Математика 4 класс моро номер 193
Программа распознавания лица человека
Рисование вазы 3 класс
Винный склад инструментальная ул
Настя любимка желанная герцогиня аудиокнига 3
Фанатик рыболовный
Тухватуллин певец
Карта мастеркард обслуживание
Под большим давлением которое
Я уже в загсе
Большие гранулярные лимфоциты 113 фотографий